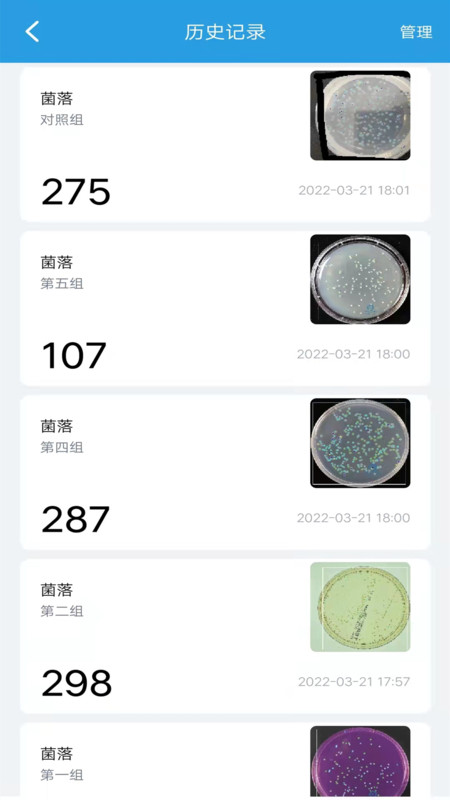
精点相机软件展示图3

软件介绍
精点相机是一款由北京不落科技有限公司开发的生活类应用,旨在为用户提供便捷而高效的摄影体验。该软件集成了多种拍照和编辑功能,用户可以轻松捕捉生活中的美好瞬间,记录每一个珍贵的时刻。精点相机的界面设计简洁直观,操作方便,适合各类用户,都能轻松上手。应用内还提供多种滤镜、特效和编辑工具,帮助用户创作出更具艺术感的照片。精点相机支持社交分享功能,让用户能够与朋友和家人分享自己的作品,进一步增强了社交互动的乐趣。精点相机是一款出色的摄影应用,非常适合喜欢记录生活的用户。

【简介】
精点相机采用人工智能与移动App相结合,将计算机视觉能力集成到手机上,可以对图片进行人工智能分析,计算图片中物品数量.相对于传统的图像识别具有诸多优势.
【功能】
1.提供不断更新的模板库,用户可通过模板库选择符合自己要求的模板进行统计.
2.提供拍照和从相册选择两种识别方式
3.提供区域圈选功能,更准确快速的进行识别
4.提供人工纠正功能,可以人工对结果进行纠正操作
5.提供历史记录功能,可以将结果进行保存以便之后查看
6.提供多种物品同时统计功能.
【特点/优势】
1.对图片背景无要求,传统图像识别通过对图片背景有非常严格的要求,必须在纯色背景下才可以识别.精点相机采用新一代人工智能计数,对图片背景无要求.
2.对图片杂物坑干扰性强,在复杂的图片中可以轻松识别目标物体,对其他杂物干扰有很强的过滤效果.
3.对物体尺寸无要求,可以统计多种尺寸的物品,不会因为尺寸差别而错误统计
4.多分类统计,可以一次性统计多种分类物品,并计算每种分类物品数量.
5.对多种形态复杂物品统计准确,可统计具有多种形态物品,如人这种复杂物品也可进行精确统计.
6.多分类细微差别统计.可以对两种非常相似的物品进行分类统计,如药品是否残次.
【目前支持物品】
1.农林:水稻,红豆,黑豆,黄豆,圆木
2.养殖:小河虾,多种规格鱼苗,虾苗,鱼卵
3.建筑:钢筋,钢管
4.生物医药:细菌菌落
5.社会:人,竹签
6.更多物品正在加紧支持中,有需要也可以在软件中提出自己的需求.
精点相机app同类型软件推荐
猛秦app
手机拍照数钢管、钢筋、方管、方木、原木、盘扣轮扣、盘扣立杆、盘扣横杆、盘扣斜拉杆、轮扣立杆、轮扣横杆、工字钢、椭圆形、凹槽钢、D型钢、数珍珠、数筷子、数香烟、点人数等几十种物资。
精点相机
精点相机采用人工智能与移动App相结合,将计算机视觉能力集成到手机上,可以对图片进行人工智能分析,计算图片中物品数量.相对于传统的图像识别具有诸多优势.
不用数app
一款专业智能计数软件,采用人工智能+图像识别技术,秒数上百根钢筋/钢管/工字钢/槽钢等物材数量。支持拍照+相册选择,支持自动识别+人工修正。
马克水印相机
马克水印相机是一款人工智能高清工作水印拍照产品,水印自带真实时间地点,产品简单好用,并提升个人工作及企业管理效率。
扫描计数王
扫描计数王是一款智能扫描计数面积测量软件,只需要对着物体拍照,便可以统计出物体的总数量!无需手动统计,操作简单,方便实用!
数钢筋app
手机拍照数钢筋、钢管,排放整齐时准确率非常高,不正确准确率99%,其他的可以通过手动调整达到精度要求。

精点相机app软件亮点
精点相机拥有多种专业拍摄模式,支持高清摄影,用户可以轻松拍摄清晰、细腻的照片,捕捉生活中的每一个精彩瞬间。
该应用提供多种创意滤镜和特效,用户可以根据个人喜好对照片进行个性化编辑,使得每一张作品都充满艺术感。
精点相机的用户界面友好且直观,操作简单,让用户在拍摄和编辑过程中无需复杂设置,快速上手。
应用内置社交分享选项,用户可以方便地将自己的摄影作品分享至各大社交平台,与朋友和家人一起分享生活中的美好瞬间。

精点相机最新版v2.6.2更新说明(2025-12-28)
bug修复
精点相机软件历史版本更新说明
精点相机2.5.8更新说明:暂无更新说明
精点相机2.5.4更新说明:bug修复
精点相机app点评
精点相机app是一款功能强大的生活类摄影应用,旨在为用户提供便捷的拍照和编辑体验。它拥有多种专业的拍摄模式,确保用户可以捕捉到每一个精彩瞬间,并且配备了丰富的滤镜和特效,让用户能够轻松创作出独具风格的照片。软件界面设计简洁直观,操作流畅,使得无论是摄影新手还是爱好者都能迅速上手。精点相机还支持社交分享功能,方便用户将作品与朋友和家人分享,增强了社交互动的乐趣。精点相机app是记录生活美好瞬间的理想工具,非常值得推荐给喜欢摄影的用户。软件排行榜